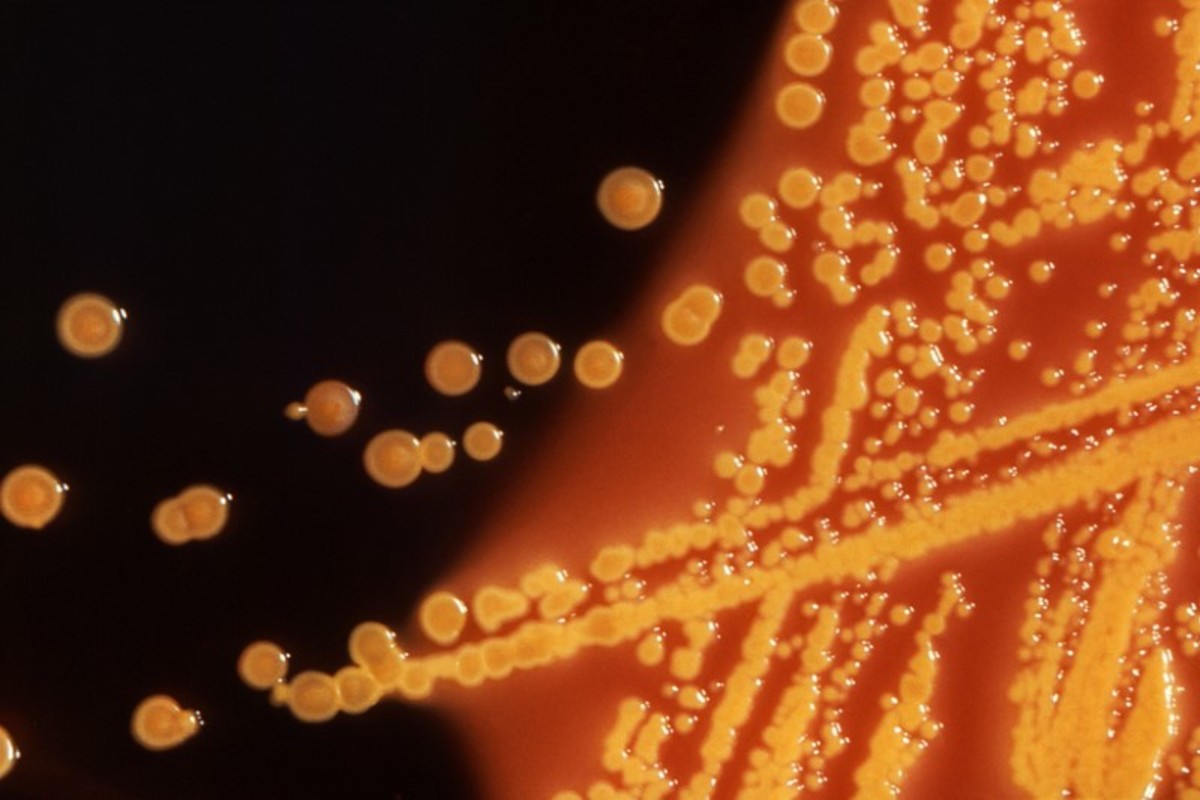

(Reuters) - Health officials in New Jersey said they are investigating an E. coli outbreak in four counties that left at least eight people hospitalized.
The New Jersey department of health said it was in preliminary stages of an investigation that was possibly associated with a restaurant chain without naming it.
However a Business Insider report citing county officials said the chain under investigation was Panera Bread.
The Panera Bread restaurant in Phillipsburg, New Jersey, is the chief focus of the probe, according to the Business Insider report.
Of the eight people hospitalized, five have been discharged, according to a statement on the state department's website.
Panera Bread, the chain that was bought by privately owned German investment firm JAB Holding in 2017, has recently been in the news for leaking customer records.
(Reporting by Nivedita Balu in Bengaluru; Editing by Shounak Dasgupta)